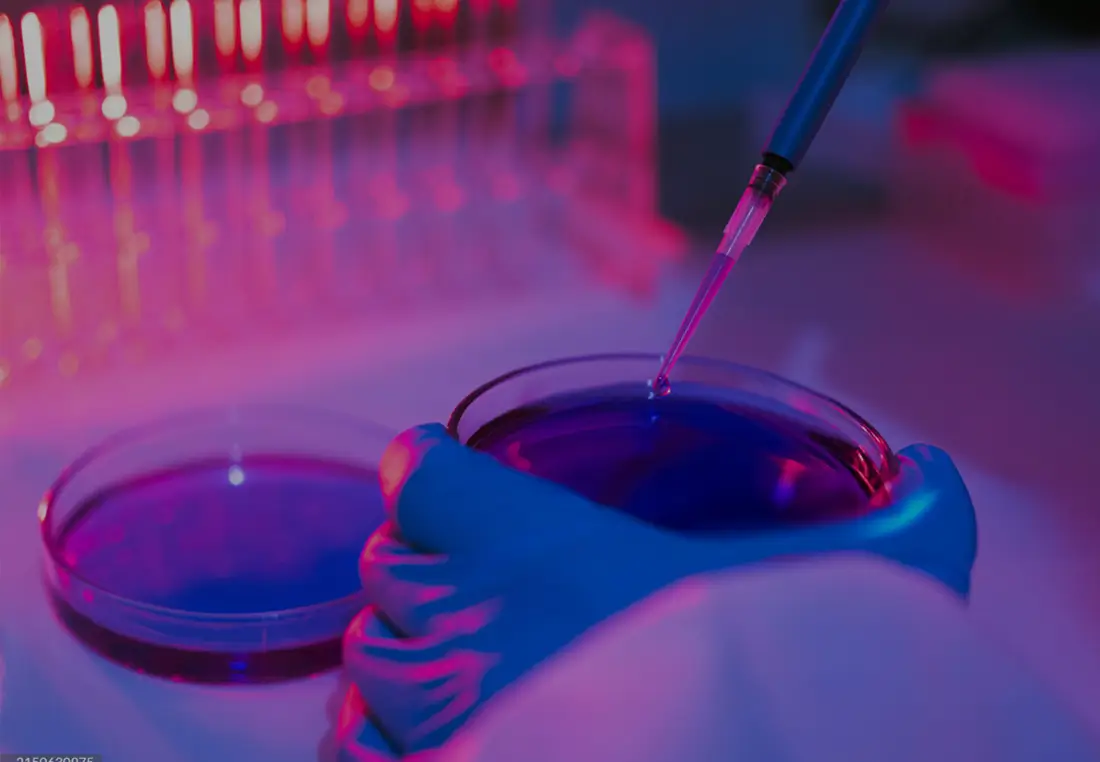

Partners in making
the world
cleaner
better
sustainable
Thermax is a global engineering company providing sustainable solutions in energy and the environment.
We are
Thermax
From curbing emissions with advanced air pollution control systems, enabling energy efficiency through clean technologies, to conserving water with cutting-edge treatment and recycling solutions, our commitment lies in fostering a world where progress and sustainability go hand in hand. With every solution, we aim to build a better tomorrow—one that thrives on responsible innovation and leaves a lasting legacy for generations to come.
60+
Years of legacy
90+
Countries served
45+
Offices globally
16
Manufacturing facilities
edge solutions
At Thermax, we are committed to forging strong, trusted partnerships with our customers. With a deep-rooted commitment to sustainability, we provide innovative and tailored energy, environment, and chemical solutions, coupled with our digital capabilities, that help industrial, commercial and urban segments achieve better resource productivity and bottom line while reducing their environmental footprint.
Industrial Products
Industrial Products
The Industrial Products segment offers solutions and services engineered to efficiently meet process heating, cooling, pollution abatement and water management requirements for various sectors.
- Air Pollution Control Systems
- Cooling and Heating Solutions
- Process Heat Solutions
- Steam Engineering Solutions
- Water and Waste Solutions
Industrial Infra
Industrial Infra
The Industrial Infra segment supports industries with utility solutions tailored to meet their specific steam and power requirements.
Discover moreGreen Solutions
Green Solutions
The Green Solutions segment focuses on providing new energy and bespoke decarbonisation offerings to industrial customers on a long-term basis.
Discover moreChemicals
Chemicals
The Chemicals segment offers resins, water treatment, and speciality chemicals, as well as construction chemicals (admixtures, protective coatings, waterproofing, industrial flooring, sealants, adhesives), to help improve processes across a spectrum of industries.

Energy Transition
Thermax’s approach to energy transition is rooted in more than five decades of deep engineering expertise and a legacy of delivering sustainable energy solutions that help industries decarbonise and thrive in a low-carbon future. As climate challenges intensify globally, Thermax recognises that there is no single solution — and this belief shapes our end-to-end capabilities across renewable energy, energy management, waste-to-energy, and clean technologies.
Innovation lies at the heart of Thermax’s energy transition capability, where pioneering research, strategic partnerships, and practical deployments converge to deliver measurable impact. From waste to energy, scaled-up bio-CNG and hybrid renewable projects to green hydrogen and digital energy management tools, our work accelerates the adoption of cleaner, smarter energy systems across industries. This reinforces Thermax’s commitment to be a trusted partner in building resilient and sustainable energy ecosystems for customers and communities worldwide.
Digital Solutions
EDGE Live, Thermax’s IIoT digital solution, delivers real-time intelligence for industrial assets, enabling customers to operate with greater reliability, efficiency, and confidence. By continuously monitoring asset performance, it detects early signs of inefficiency or potential failure and recommends the right corrective actions. This proactive approach helps reduce unplanned downtime, improve operational performance, and support decarbonisation.
Powered by advanced AI and machine learning models that continuously learn from real operating data, EDGE Live analyses large volumes of information to uncover patterns and accurately predict performance outcomes. Using techniques such as decision trees, neural networks, and association rules, these insights are translated into clear recommendations and task-based actions for teams. Combined with Thermax’s expertise in energy and environment solutions, EDGE Live goes beyond digital monitoring to deliver expert guidance that drives smarter, future-ready operations.
Thermax Serve
Drawing on decades of industry expertise, Thermax Serve offers a comprehensive portfolio of solutions aimed at enhancing operational reliability, improving system performance and extending equipment life. What distinguishes Thermax Serve is its ability to support equipment from all manufacturers, not just Thermax, thereby widening its impact and relevance across the industrial landscape.
Delivered through a network of trained professionals, the platform integrates capabilities such as annual service support, automation and fuel conversion upgrades, waste heat recovery, advanced welding repairs, safety and life assessments, operational health checks, troubleshooting, and genuine spares. Together, these services ensure reliable support, faster resolution, regulatory compliance, and sustained performance—driving higher productivity, lower operating costs, and long-term value backed by the Thermax brand.
Biomass Centre of Excellence
The Thermax Biomass Centre of Excellence represents Thermax’s commitment to delivering best-in-class biomass heating solutions through extensive experience in fuels, advanced combustion technologies, and continuous research, innovation, and development. It brings together deep technical knowledge of biomass fuels (including agro-residues, woody biomass, briquettes, pellets, and industrial waste) and their chemical and physical properties to design efficient, reliable biomass-based heating systems.
Serving as a hub for innovation and collaboration, the Centre supports customers across the entire lifecycle—from fuel selection and technology evaluation to system integration, optimisation, and performance enhancement. Through continuous research, technology development, and knowledge sharing, the Biomass Centre of Excellence helps industries maximise efficiency and uptime while transitioning to cleaner, sustainable energy solutions with confidence.
Research and Development
The Research, Technology and Innovation Centre (RTIC) of Thermax advances next-generation technologies for a cleaner, more sustainable future. Our R&D spans three areas: Carbon Capture and Utilisation (CCU), Green Hydrogen and Electrochemical Technologies, and Biofuels and Bioprocessing.
In CCU, we are developing low-energy solvents, solid-state absorbents, CO₂ electrolysers, and simulation frameworks to enable carbon-to-fuel pathways. Our work in green hydrogen and electrochemical technologies includes solid oxide and anion exchange membrane electrolysers, hydrogen compression, coal-to-chemicals conversion, and waste-to–SAF (sustainable aviation fuel)/green hydrogen/CBG (compressed biogas) solutions, supported by gen-AI–enabled design and optimisation. In biofuels and bioprocessing, we focus on biohydrogen, bio-waste to CNG, waste-to-fuel and waste-to-energy technologies, along with sustainable aviation fuel.
Green Hydrogen
Thermax’s green hydrogen capability combines proven and next-generation electrolyser technologies to support industrial decarbonisation, enabling scalable adoption from pilot to gigawatt-scale across industries. Backed by advanced manufacturing, strategic partnerships, and a strong project track record, Thermax is well aligned with India’s National Green Hydrogen Mission targeting 5 million metric tonnes by 2030.
In collaboration with HydrogenPro, Thermax offers indigenised alkaline water electrolysis (AWE) systems that are reliable, scalable, and ready for large-scale deployment, supported by local manufacturing and lifecycle expertise. Complementing this is Thermax’s partnership with Ceres Power to deliver Solid Oxide Electrolysis (SOEC), a next-generation technology offering superior efficiency through high-temperature electrolysis, suited for energy-intensive industries with access to waste heat.
Urthh
Urthh, a dedicated business model under Thermax Water and Waste Solutions business, is designed to address the pressing challenges of urban water management. As cities face rising water scarcity, regulatory pressures, and the need for sustainable solutions, Urthh aims to be a transformative force in urban water conservation, strengthening both environmental responsibility and economic resilience.
Urthh provides end-to-end water and wastewater solutions, including technical audits, plant improvements and upgrades, integrated IoT-enabled monitoring, and water recycling systems. Our goal is to ensure that urban spaces minimise dependency on external water sources, adapt to water recycling and reuse, comply with stringent environmental regulations, and optimise operational efficiency while reducing costs.
across industries
Backed by a legacy of trust and a commitment towards a sustainable future, Thermax empowers industries to transform responsibly. Through our expertise in pollution control, energy and water management, and renewable solutions, we help customers reduce emissions, optimise resource use, and enhance operational efficiency, while lowering costs.
Thermax's CLCT boosts reliability and performance of heat exchangers for an IT major
Thermax sets a record by installing and commissioning a bi-drum boiler in just 40 days for a pharmaceutical major in Indonesia
Thermax’s ZLD technology enables glass manufacturer reduce freshwater consumption
Thermax’s 175 TPH radiant boiler enables a fertiliser company to achieve uninterrupted steam generation and optimised performance
Our commitment to creating stakeholder value is reflected in our strategy, fundamentals and performance. Stay up to date on key financial information, reports, and upcoming events.
Latest publication & results





